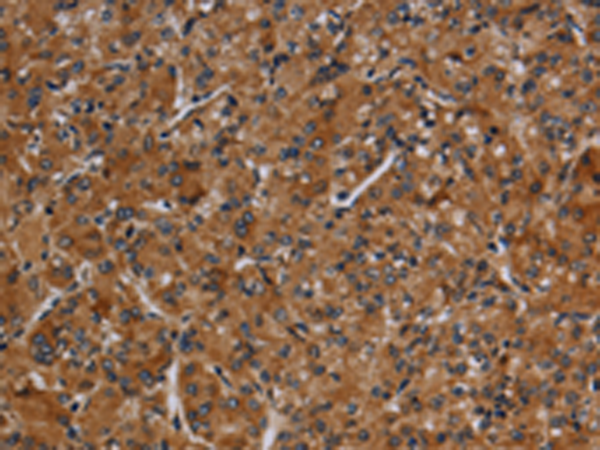

-
分类: 科研抗体货号: P12032别名: FH3; PC9; NARC1; LDLCQ1; NARC-1; HCHOLA3应用: WB反应种属: Human
-
分类: 科研抗体货号: P12016别名: CP12; P3-450; P450(PA)应用: WB,IHC反应种属: Human
-
分类: 科研抗体货号: P11990别名: NGR; NOGOR应用: IHC反应种属: Human, Mouse, Rat
-
分类: 科研抗体货号: P12031别名: PCDH-BETA15应用: IHC反应种属: Human
-
分类: 科研抗体货号: P12014别名: P2U; HP2U; P2U1; P2UR; P2Y2; P2RU1; P2Y2R应用: WB,IHC反应种属: Human, Mouse, Rat
-
分类: 科研抗体货号: P11987别名: NMT应用: WB,IHC反应种属: Human, Mouse, Rat
-
分类: 科研抗体货号: P12030别名: JMJD2B; TDRD14B应用: IHC反应种属: Human
-
分类: 科研抗体货号: P12009别名: OX; PPOX; NRCLP1应用: WB反应种属: Human, Mouse
-
分类: 科研抗体货号: P11986别名: NOD6; NALP9; PAN12; CLR19.1应用: IHC反应种属: Human
-
分类: 科研抗体货号: P12029别名:应用: WB,IHC反应种属: Human, Mouse

鄂公网安备42018502007531号
鄂公网安备42018502007531号

